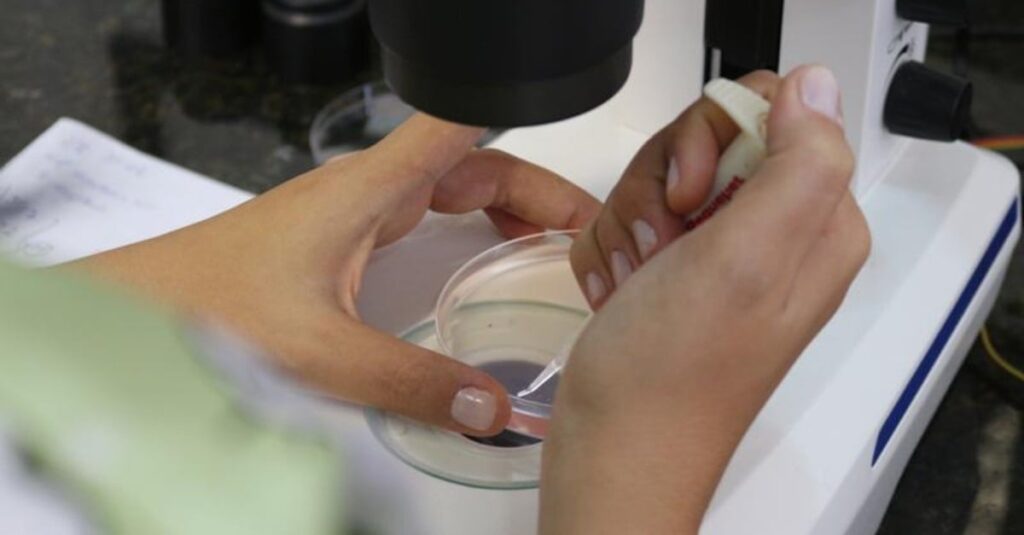
Como multiplicar animais? Consulta pública na agricultura. 5 Agricultura abre consulta pública sobre procedimentos de multiplicação animal

Frigoríficos: como conseguir preços mais baixos?
A Importância do Mercado do Boi Gordo Tentativas de Compra Abaixo da Referência Média A Pressão dos Frigoríficos e a Demanda de Carne Bovina no Mercado O mercado físico do boi gordo voltou a apresentar tentativas de compra abaixo da referência média no decorrer da terça-feira (31), em São Paulo, Mato Grosso do Sul e […]
Frigoríficos: como conseguir preços mais baixos? Read More »